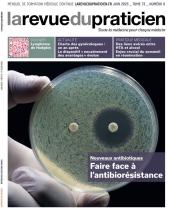

- 2023 -
Décembre
- La Revue du Praticienn°10
- La Revue du Praticien Médecine Généralen°1082
- 2023 -
Novembre
- La Revue du Praticien Médecine Généralen°1081
- La Revue du Praticienn°9
- 2023 -
Octobre
- La Revue du Praticien Médecine Généralen°1080
- La Revue du Praticienn°8
- 2023 -
Septembre
- La Revue du Praticien Médecine Généralen°1079
- La Revue du Praticienn°7
- 2023 -
Juin
- La Revue du Praticien Médecine Généralen°1078
- La Revue du Praticienn°6
- 2023 -
Mai
- La Revue du Praticienn°5
- La Revue du Praticien Médecine Généralen°1077